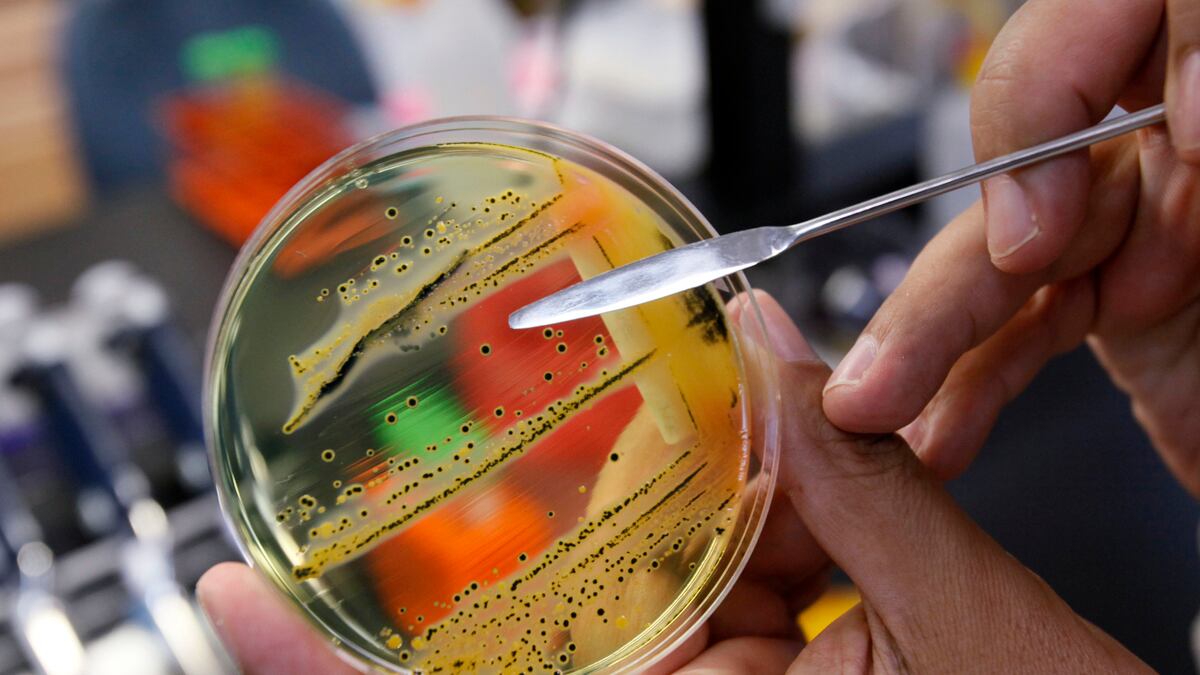
cheats/2011/08/03/salmonella-surge-linked-to-meat-giant/salmonella-cheat_bnq35m

Looks like it was the turkey after all. Meat giant Cargill has recalled 36 million pounds of ground turkey after the Centers for Disease Control found that Cargill's meat samples were contaminated with the same strains of salmonella connected to the recent outbreak. So far, the salmonella surge has caused one death and 76 other cases of illness across the U.S. But since the samples tested had not directly caused any illness, the Agriculture Department has not been able to name Cargill the culprit. An antibiotic-resistant salmonella superbug is also on the rise in Europe, though officials believe it first came from Africa.
Read it at CBS News